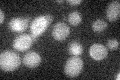
YMR302C

View description
Integral inner mitochondrial membrane protein with a role in maintaining mitochondrial nucleoid structure and number; mutants exhibit an increased rate of mitochondrial DNA escape; shows some sequence similarity to exonucleases
Localization:
Intensity:
Fold change:
Significance:
-
C’ GFP library in SD
below threshold16.54 -
N' NOP1pr-GFP in SD

mitochondria49.6049 -
N' TEF2pr-mCherry in SD

Blank73.922 -
N' NATIVEpr-GFP in SD

mitochondria21.4776 -
N' TEF2pr-VC and Cyto-VN in SD

#N/A0 -
C’ GFP library in SD+DTT

cytosol14.250.86No -
C’ GFP library in SD+H2O2

cytosol14.920.9No -
C’ GFP library in Starvation Media

cytosol14.910.9No -
C’ GFP library on the background of Pup2-DaMP

below threshold -
C’ GFP library on the background of CCT mutant

below threshold14.50320.876339No
